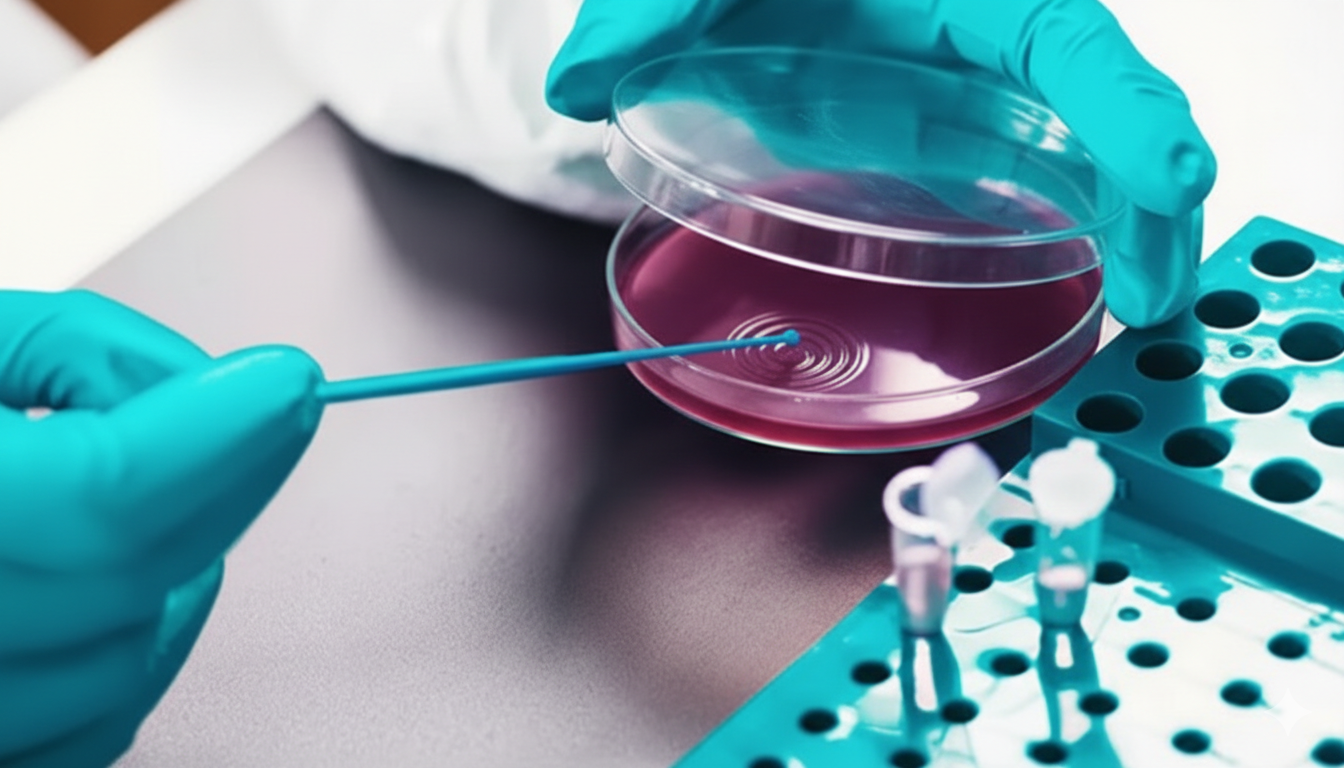

TriStains – Premium Laboratory Stains & Indicators
High-quality stains, dyes, and indicators engineered for precise color performance in life-science labs across histology, cytology, microbiology, and hematology.
TriStains
Excellent color performance of desired components of cells and tissue in life science laboratories.
VIEW ALL PRODUCTSTriStains
Histological stains that offer range of stains used in Histology,Cytology, microbiology and Hematology laboratories.
VIEW ALL PRODUCTSHigh-quality stains, dyes, and indicators engineered for precise color performance in life-science labs across histology, cytology, microbiology, and hematology.
Trusted Lab Supplies

Fast-acting reagents designed for rapid reactions and efficient workflows.

Catalog: SS1056415

Catalog: SS1056515

Catalog: SS1056615

Catalog: SS1056715

Catalog: SS1056815

Catalog: SS1056915

Catalog: SS1057015

Catalog: SS1057115

Catalog: SS1057215

Catalog: SS1057415

Catalog: SS1057515

Catalog: SS1057615

Catalog: SS1057715

Catalog: SS1057815

Catalog: SS1057915

Catalog: SS1058015

Catalog: SS1058115

Catalog: SS1058215

Catalog: SS1056315

Catalog: SS1049415

Catalog: SS1049515

Catalog: SS1049315

Catalog: SS1049215

Catalog: SS1049115

Catalog: SS1032215

Catalog: SS1029015

Catalog: SS1028615
Quality-tested solutions designed to support accurate analytical and staining applications.

Catalog: TSL11751

Catalog: TSL11752

Catalog: TSL11753

Catalog: TSL11754

Catalog: TSL11755

Catalog: TSL11756

Catalog: TSL11757

Catalog: TSL11758

Catalog: TSL11759

Catalog: TSL11760

Catalog: TSL11761

Catalog: TSL11762

Catalog: TSL11763

Catalog: TSL11764

Catalog: TSL11765

Catalog: TSL11766

Catalog: TSL11767

Catalog: TSL11768

Catalog: TSL11769

Catalog: TSL11770

Catalog: TSL11771

Catalog: TSL11772

Catalog: TSL11774

Catalog: TSL11775

Catalog: TSL11776

Catalog: TSL11777
High-purity solvents designed for sample prep, staining support, and lab procedures.

Catalog: TSV11501

Catalog: TSV11502

Catalog: TSV11503

Catalog: TSV11504

Catalog: TSV11505

Catalog: TSV11506

Catalog: TSV11507

Catalog: TSV11508

Catalog: TSV11509

Catalog: TSV11510

Catalog: TSV11511

Catalog: TSV11512

Catalog: TSV11513

Catalog: TSV11514

Catalog: TSV11515

Catalog: TSV11516

Catalog: TSV11517

Catalog: TSV11518
Reliable solid and solution stains that enhance cellular and tissue visualization for accurate microscopic analysis.

Catalog: S10039

Catalog: S10066

Catalog: S10068

Catalog: S10095

Catalog: S10097

Catalog: S10117

Catalog: S10126

Catalog: S10197

Catalog: S10001

Catalog: S10067

Catalog: S10070

Catalog: S10071

Catalog: S10072

Catalog: S10081

Catalog: S10102

Catalog: S10111

Catalog: S10174

Catalog: S10116

Catalog: S10118

Catalog: S10119

Catalog: S10125

Catalog: S10173

Catalog: S10181

Catalog: S10179

Catalog: S10180

Catalog: S10002

Catalog: S10003

Catalog: S10004

Catalog: S10005

Catalog: S10006

Catalog: S10007

Catalog: S10008

Catalog: S10009

Catalog: S10010

Catalog: S10011

Catalog: S10012

Catalog: S10013

Catalog: S10014

Catalog: S10015

Catalog: S10016

Catalog: S10017

Catalog: S10018

Catalog: S10019

Catalog: S10020

Catalog: S10021

Catalog: S10022

Catalog: S10023

Catalog: S10024

Catalog: S10025

Catalog: S10026

Catalog: S10027

Catalog: S10028

Catalog: S10029

Catalog: S10030

Catalog: S10031

Catalog: S10032

Catalog: S10033

Catalog: S10034

Catalog: S10035

Catalog: S10036

Catalog: S10037

Catalog: S10038

Catalog: S10040

Catalog: S10041

Catalog: S10042

Catalog: S10043

Catalog: S10044

Catalog: S10045

Catalog: S10046

Catalog: S10047

Catalog: S10048

Catalog: S10049

Catalog: S10050

Catalog: S10051

Catalog: S10052

Catalog: S10053

Catalog: S10054

Catalog: S10055

Catalog: S10056

Catalog: S10057

Catalog: S10058

Catalog: S10059

Catalog: S10060

Catalog: S10061

Catalog: S10062

Catalog: S10063

Catalog: S10064

Catalog: S10065

Catalog: S10069

Catalog: S10073

Catalog: S10074

Catalog: S10075

Catalog: S10076

Catalog: S10077

Catalog: S10078

Catalog: S10079

Catalog: S10080

Catalog: S10082

Catalog: S10083

Catalog: S10086

Catalog: S10087

Catalog: S10088

Catalog: S10089

Catalog: S10090

Catalog: S10091

Catalog: S10092

Catalog: S10093

Catalog: S10094

Catalog: S10096

Catalog: S10098

Catalog: S10099

Catalog: S10100

Catalog: S10101

Catalog: S10103

Catalog: S10104

Catalog: S10105

Catalog: S10106

Catalog: S10107

Catalog: S10108

Catalog: S10109

Catalog: S10112

Catalog: S10114

Catalog: S10115

Catalog: S10120

Catalog: S10121

Catalog: S10122

Catalog: S10123

Catalog: S10124

Catalog: S10127

Catalog: S10128

Catalog: S10129

Catalog: S10130

Catalog: S10131

Catalog: S10132

Catalog: S10133

Catalog: S10134

Catalog: S10135

Catalog: S10136

Catalog: S10137

Catalog: S10138

Catalog: S10139

Catalog: S10140

Catalog: S10141

Catalog: S10142

Catalog: S10143

Catalog: S10144

Catalog: S10145

Catalog: S10146

Catalog: S10147

Catalog: S10148

Catalog: S10149

Catalog: S10150

Catalog: S10151

Catalog: S10153

Catalog: S10154

Catalog: S10155

Catalog: S10157

Catalog: S10158

Catalog: S10159

Catalog: S10160

Catalog: S10161

Catalog: S10162

Catalog: S10163

Catalog: S10165

Catalog: S10166

Catalog: S10167

Catalog: S10168

Catalog: S10169

Catalog: S10170

Catalog: S10171

Catalog: S10172

Catalog: S10175

Catalog: S10176

Catalog: S10177

Catalog: S10178

Catalog: S10182

Catalog: S10183

Catalog: S10184

Catalog: S10185

Catalog: S10188

Catalog: S10189

Catalog: S10190

Catalog: S10191

Catalog: S10192

Catalog: S10193

Catalog: S10194

Catalog: S10195

Catalog: S10196

Catalog: S10198

Catalog: S10200

Catalog: S10110

Catalog: S10232
Convenient and prepared stain solutions optimized for consistent and reproducible lab results.

Catalog: SS10251

Catalog: SS10252

Catalog: SS10260

Catalog: SS10261

Catalog: SS10262

Catalog: SS10263

Catalog: SS10270

Catalog: SS10271

Catalog: SS10272

Catalog: SS10277

Catalog: SS10278

Catalog: SS10279

Catalog: SS10280

Catalog: SS10286

Catalog: SS10287

Catalog: SS10290

Catalog: SS10292

Catalog: SS10293

Catalog: SS10294

Catalog: SS10295

Catalog: SS10296

Catalog: SS10297

Catalog: SS10298

Catalog: SS10306

Catalog: SS10307

Catalog: SS10310

Catalog: SS10314

Catalog: SS10315

Catalog: SS10316

Catalog: SS10317

Catalog: SS10318

Catalog: SS10319

Catalog: SS10320

Catalog: SS10321

Catalog: SS10322

Catalog: SS10491

Catalog: SS10492

Catalog: SS10493

Catalog: SS10494

Catalog: SS10495

Catalog: SS21001

Catalog: SS10496

Catalog: SS10308
Precisely formulated indicators for clear endpoint detection in titrations and analytical workflows.

Catalog: I10503

Catalog: I10504

Catalog: I10505

Catalog: I10506

Catalog: I10507

Catalog: I10508

Catalog: I10511

Catalog: I10512

Catalog: I10513

Catalog: I10526

Catalog: I10527

Catalog: I10538

Catalog: I10539

Catalog: I10540

Catalog: I10541

Catalog: I10542

Catalog: I10546

Catalog: I10550

Catalog: I10555

Catalog: I10556

Catalog: I10557

Catalog: I10569

Catalog: I10570

Catalog: I10574

Catalog: I10575

Catalog: I10576

Catalog: I10580

Catalog: DI10737

Catalog: DI10726

Catalog: I10579

Catalog: I10578

Catalog: I10577
Precisely formulated indicator solutions for clear and accurate endpoint detection.

Catalog: IS10751

Catalog: IS10752

Catalog: IS10753

Catalog: IS10754

Catalog: IS10755

Catalog: IS10756

Catalog: IS10757

Catalog: IS10758

Catalog: IS10759

Catalog: IS10760

Catalog: IS10761

Catalog: IS10762

Catalog: IS10763

Catalog: IS10764

Catalog: IS10765

Catalog: IS10766

Catalog: IS10767

Catalog: IS10768

Catalog: IS10769

Catalog: IS10770

Catalog: IS10771

Catalog: IS10774

Catalog: IS10775

Catalog: IS10776

Catalog: IS10777

Catalog: IS10779

Catalog: IS10781

Catalog: IS10782

Catalog: IS10783

Catalog: IS10784

Catalog: IS10785

Catalog: IS10786

Catalog: IS10787

Catalog: IS10788

Catalog: IS10789

Catalog: IS10790

Catalog: IS10791

Catalog: IS10792

Catalog: IS10793

Catalog: IS10794

Catalog: IS10797

Catalog: IS10798

Catalog: IS10799

Catalog: IS10800

Catalog: IS10801

Catalog: IS10802

Catalog: IS10803

Catalog: IS10804

Catalog: IS10805

Catalog: IS10806

Catalog: IS10807

Catalog: IS10809

Catalog: IS10810

Catalog: IS10812

Catalog: IS10813

Catalog: IS10814

Catalog: IS10815

Catalog: IS10816

Catalog: IS10817

Catalog: IS10818

Catalog: IS10819

Catalog: IS10820

Catalog: IS10821

Catalog: IS10822

Catalog: IS10823

Catalog: IS10824

Catalog: IS10825

Catalog: IS10827

Catalog: IS10828

Catalog: IS10829

Catalog: IS10830

Catalog: IS10831

Catalog: IS10832

Catalog: IS10833

Catalog: IS10834

Catalog: IS10835

Catalog: IS10836

Catalog: IS10837

Catalog: IS10838

Catalog: IS10839

Catalog: IS10840

Catalog: IS10841

Catalog: IS10842

Catalog: IS10843

Catalog: IS10844

Catalog: IS10845

Catalog: IS10846

Catalog: IS10847

Catalog: IS10848

Catalog: IS10849

Catalog: IS10850

Catalog: IS10851

Catalog: IS10852

Catalog: IS10853

Catalog: IS10854

Catalog: IS10855

Catalog: IS10856

Catalog: IS10857

Catalog: IS10858

Catalog: IS10859

Catalog: IS10860

Catalog: IS10861

Catalog: IS10864

Catalog: IS10865




